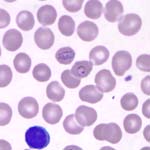

P.knowlesi được phát hiện khi nào?
Cox-Sigh và cộng sự đã phát hiện ca sốt rét nhiễm P.knowlesi đầu tiên ở khỉ Macaque đuôi dài (tên khoa học là: Macaca fascicularis) khi nhập khẩu từ Singapore đến Ấn Độ vào năm 1931. Một năm sau đó (1932), Knowles và Das Gupta đã thành công trong việc gây nhiễm thực nghiệm truyền P.knowlesi từ khỉ sang người. Ca bệnh nhiễm P.knowlesi ở người được mô tả đầu tiên vào năm 1965 tại Mỹ trên một người lính trở về từ Malaysia.
Vào năm 1960, Eyles đã thành công trong việc truyền tác nhân gây bệnh sốt rét ở khỉ là P.cynomolgi cho người trên thực nghiệm.Năm 1966 bằng cách cho muỗi đốt máu có nhiễm ký sinh trùng sốt rét (KSTSR) rồi cho đốt người, tác giả Granharm cũng đã chứng minh rằng các loài KSTSR ở khỉ như P.iuni,, P.knowlesi đều có khả năng truyền bệnh cho người.
Mãi đến năm 1971 chỉ có 2 trường hợpnhiễm P.knowlesi ở người được báo cáo (Chin, 1965 và Yap, 1971), tất cả đều sống ở Peninsular - Malaysia. Sau đó Cox-Sigh và công sự đã tiến hành một nghiên cứu kéo dài từ tháng 3/2000 đến tháng 11/2002 tại Malayssia, Kết quả cho thấy rằngtrong số 208 ca bệnh được chẩn đoán ban đầu là nhiễm P.malariae thì có đến 120 ca được xác địnhlà P.knowlesi bằng kỹ thuật PCR (Nested PCR assay). Nhiều trường hợp nhiễm P.knowlesi sau đó cũng được phát hiện tại Kanip, Sarawak, Malaysia năm 2004 (Singh và cs). Vào năm này một ca bệnh do loài KSTSR này gây nên cũng được phát hiện trên một bệnh nhân làm việc trong rừng ở biên giới giữa Thái và Myanmar (Jongwutiwes). Một nghiên cứu khác cũng cho hay người bệnh nhiễm P.knowlesi cũng được phát hiện tại Philippine.
Hình thể P.knowlesi và thuốc điều trị
Hình thể của P.knowlesi trên tiêu bản khi soi dưới kính hiển vi tương tự như P.malariae. Đây là một trong những yếu tố gây nhầm lẫn P.knowlesi và P.malariae khi chẩn đoán dựa trên phương pháp nhuộm Giêmsa truyền thống. Theo TS. Janet thuộc Đại học Sarawar, Malaysia từ năm 2001 đến năm 2006, trong tổng số 960 lam máu của các bệnh nhân sốt rét nhập viện thì có đến 228 lam được chẩn đoán nhầm là P.malariae trong 266 ca được xác định là P.knowlesi bằng DNA sau đó. Do đó, để phân biệt chính xác 2 loài ký sinh trùng này nhất thiết phải sử dụng các kỹ thuật sinh học phân tử hoặc DNA.
Nhiều nghiên cứu cho thấy rằng P.knowlesi vẫn đáp ứng tốt với Chloroquine và Primaquine.
|  |
Hình thể P.knowlesi trên tiêu bản | nhuộm giêmsa giọt mỏng (trái) và giọt dày (phải) |
Trung gian truyền bệnh P.knowlesi
Nghiên cứu ban đầu của Wharton và Eyles (1961) cho rằng trung gian truyền bệnh P.knowlesi từ khỉ cho người là An.hackeri (thuộc nhóm Luecosphyrus), nhưng sau đó người ta khám phá ra rằng An.hackeri không có ái tính với người và chủ yếu truyền bệnh sốt rét cho khỉ mà thôi (Reid và Weitz, 1961). Một nghiên cứu tiếp đó của Wharton (1962) cho thấy rằng An.latens (nhóm Leucosphyrus) chính là vector truyền bệnh chính P.inui cho khỉ và P.knowlesi cho cả khỉ và người. An.latens có tập tính đốt mồi từ khi trời tối cho đến gần sáng và đỉnh cao là lúc nữa đêm. Loài muỗi này hoạt động chủ yếu trong rừng và bìa rừng nhưng có xu hướng vào nơi ở của người sống bìa rừng và trong rừng để tìm mồi đốt máu (I.Vithylingam, 2005). Kết quả nghiên cứu này cũng cho thấy rằng tỷ lệ nhiễm thoa trùng của An.latens là 0.7% ở bìa rừng và 1.4% trong rừng và chỉ số EIR (Entomological inoculation rate) là 11.98 ở bìa rừng và 14.10 ở trong rừng.
Phân bố của P.knowlesi
Dựa trên những nghiên cứu về đặc điểm dịch tễ của P,knowlesi và sự phân bố của nhóm Anopheles Luecosphyrus. Cho đến nay P.knowlesi, được xem là loài ký sinh sinh trùng thứ năm truyền bệnh ở người, chỉ lan turyền tại khu vực Đông Nam Á.
|
Sự phân bố của nhóm Anopheles leucosphyrus |
Loài Anopheles nào là trung gian truyền bệnh Plasmodium knowlesi ở Việt Nam?
Theo tác giả Peter Van de Edel và cộng sự ở Việt Nam, trong số 95 ca sốt rét do P.malariae (PCR) thì có 3 trường hợp được xác định là P.knowlesi (cloning & sequence) tại tỉnh Ninh Thuận (2 trẻ em 2-3 tuổi và một thanh niên 27 tuổi). Những bệnh nhân này đều không có triệu chứng lâm sàng của bệnh sốt rét và họ sống, làm việc liên quan đến rừng.
Như vậy phải chăng An.dirus hay một loài muỗi nào khác thuộc nhóm Anopheles luecosphyrus có mặt ở khu vực miền Trung – Tây Nguyên có khả năng truyền P.knowlesi từ khỉ sang người ở Việt Nam?
Tài liệu tham khảo:
1. Chin W, Contacos PG, Coatney RG, Kimbal HR. (1965). "A naturally acquired quotidian-type malaria in man transferable to monkeys". Science 149: 865.
2. Yap FL, Cadigan FC, Coatney GR. (1971). "A presumptive case of naturally occurring Plasmodium knowlesimalaria in man in Malaysia". Trans R Soc Trop Med Hyg 65 (6): 839–40.
3. Singh B, Lee KS, Matusop A, Radhakrishnan A, Shamsul SSG, Cox-Singh J, Thomas A, Conway DJ (2004). "A large focus of naturally acquired Plasmodium knowlesi infections in human beings". Lancet 363: 1017–24.
4. Jongwutiwes S, Putaporntip C, Iwasaki T, Sata T, Kanbara H. (2004). "Naturally acquired Plasmodium knowlesi malaria in human, Thailand". Emerg Infect Dis 10 (12): 2211–3.
5. Vythilingam I, Tan CH, Asmad M, Chan ST, Lee KS, Singh B. (2006). "Natural transmission of Plasmodium knowlesi to humans by Anopheles latens in Sarawak, Malaysia". Trans R Soc Trop Med Hyg 100: 1087–88.
6. Wharton RH, Eyles DE. (1961). "Anopheles hackeri, a vector of Plasmodium knowlesiin Malaya". Science 134: 279–80.
7. "Plasmodium knowlesi Malaria in Humans Is Widely Distributed and Potentially Life Threatening". Clinical Infectious Diseases (University of Chicago Press/Infectious Diseases Society of America) 46: 165—171.
8. Plasmodium knowlesi: The Fifth Human Malaria Parasite – N.J.White, Center for Vaccinologyand Tropical Medicine, Oxford, UK (Editorial Commentary).
9. Is a monkey malaria from Borneo an emerging human disease? Thomas F McCutChan. National Allergy and Infectious Diseases, USA (Editorial).
10. First report on human P.knowlesi infections in Vietnam Peter Van de Eede1, Hong Nguyen Van, Chantal Van Overmeir, Indra Vythilingam, Thang Ngo Duc, Hung Le Xuan, Hung Nguyen Manh, Umberto D'alseeandro, Annette Erhart.